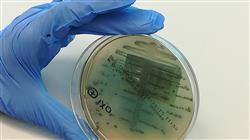
##IMAGE##

Университетская квалификация
Крупнейший в мире медицинский факультет”
Презентация
Вы сможете эффективно выявлять факторы риска сердечно-сосудистых заболеваний, что будет способствовать ранней диагностике, и все это благодаря этой передовой 100% онлайн-программе"
Заболевание периферических артерий – это хроническая патология, поражающая кровеносные сосуды, снабжающие кровью конечности. Эта патология обычно связана с такими факторами риска, как табакокурение, диабет и высокий уровень холестерина. При появлении таких важных симптомов, как перемежающаяся хромота, потеря мышечной массы или изменения кожи, специалистам необходимо применять самые современные методы лечения, направленные на улучшение качества жизни людей.
Чтобы помочь им в этом, TECH организовал Университетский курс, который позволит оптимизировать вмешательство в лечение кардиореспираторных заболеваний. Разработанная опытными преподавателями, программа обучения будет посвящена хроническим заболеваниям, включая дислипидемию и обструктивное апноэ сна.
В соответствии с этим в программе рассматривается подход к патологиям с учетом таких факторов, как диета, органические последствия и даже новые методы лечения с использованием инновационной фармакологии, которые были разработаны в последнее время. Кроме того, особое внимание будет уделено тому, как специалисты могут улучшить ведение сложных случаев, используя современные технологии и компьютеризированные медицинские записи.
Для того чтобы закрепить эти знания, методология этой программы усиливает ее инновационный характер. TECH предлагает 100% онлайн образовательную среду, где единственным требованием является наличие у студентов электронного устройства с доступом в Интернет, чтобы расширить свои знания и приобрести новые навыки для обогащения своей клинической практики.
Стоит отметить, что в университетской программе применяется инновационная методология Relearning, основанная на повторении ключевых понятий для закрепления знаний и облегчения процесса обучения. Таким образом, сочетание гибкости и эффективного педагогического подхода делает программу очень доступной. Также, что программа включает в себя подробный мастер-класс, который проводит престижный приглашенный международный лектор, что позволит специалистам развить передовые клинические навыки.
Приглашенный авторитетный международный лектор проведет подробный мастер-класс по самым современным методам лечения для точного мониторинга легочного сердца"
Данный Университетский курс в области кардиореспираторных патологий у пациентов со сложной хронической патологией содержит самую полную и современную научную программу на рынке. Основными особенностями обучения являются:
- Разбор практических кейсов, представленных экспертами в области облегчения состояния пациентов со сложными хроническими заболеваниями
- Наглядное, схематичное и исключительно практическое содержание курса предоставляет научную и практическую информацию по тем дисциплинам, которые необходимы для осуществления профессиональной деятельности
- Практические упражнения для самооценки, контроля и улучшения успеваемости
- Особое внимание уделяется инновационным методологиям
- Теоретические занятия, вопросы эксперту, дискуссионные форумы по спорным темам и самостоятельная работа
- Учебные материалы курса доступны с любого стационарного или мобильного устройства с выходом в интернет
Вы будете предлагать инновационные предложения по улучшению лечения основных хронических кардиореспираторных заболеваний"
В преподавательский состав программы входят профессионалы из данного сектора, которые привносят в обучение опыт своей работы, а также признанные специалисты из ведущих сообществ и престижных университетов.
Мультимедийное содержание программы, разработанное с использованием новейших образовательных технологий, позволит специалисту проходить обучение с учетом контекста и ситуации, т.е. в симулированной среде, обеспечивающей иммерсивный учебный процесс, запрограммированный на обучение в реальных ситуациях.
Структура этой программы основана на проблемно-ориентированном обучении, с помощью которого специалист должен попытаться разрешать различные ситуации из профессиональной практики, возникающие в течение учебного курса. В этом специалистам поможет инновационная интерактивная видеосистема, созданная признанными экспертами.
Вы хотите специализироваться на работе с пациентами с вальвулопатиями? Добейтесь этого за 6 недель с помощью этой революционной программы"

Воспользуйтесь всеми преимуществами методики Relearning, которая позволит вам организовать свое время и темп обучения, адаптировав его к своему расписанию"
Цели
Этот учебный план позволит студентам получить глобальное и всестороннее представление о каждой из естественных стадий хронических заболеваний. Таким образом, студенты смогут определить направления совершенствования в лечении этих патологий, предлагая индивидуальные услуги высочайшего качества. Они также будут использовать новые технологии для пациентов со сложными потребностями. С другой стороны, студенты будут развивать свой критический дух и способность к инновациям, чтобы предложить решения, которые приведут к большей интеграции между междисциплинарными командами, обеспечивающими уход за пациентами с хроническими патологиями.

Вы будете использовать новейшие препараты для лечения таких заболеваний, как дислипидемия, артериальная гипертензия и обструктивное апноэ сна"
Общие цели
- Сформировать глобальное видение и комплексный подход к каждой из фаз естественной истории хронических заболеваний
- Проанализировать и вмешаться в лечение данных кардиореспираторных патологий с целью достижения лучшего профилактического контроля и лучшего ведения этих заболеваний
- Разработать стратегии по борьбе с хроническими заболеваниями, которые покончат с традиционным разделением между здравоохранением и социальным уходом
- Обосновать идею о том, что центральным элементом моделей ведения хронических заболеваний является активный и информированный пациент, взаимодействующий с квалифицированной и проактивной командой специалистов
Конкретные цели
- Определить области для улучшения ухода за больными хроническими кардиореспираторными заболеваниями
- Предложить более тесную интеграцию между первичным и стационарным лечением, медсестрами, пациентами и врачами
- Повысить эффективность управления случаями, использования технологий и компьютеризированных медицинских карт при уходе за хроническими пациентами со сложными потребностями
- Обосновать создание или объединение больничных бригад для поддержки хирургических служб при уходе за пациентами с хроническими заболеваниями

Начните получать первоклассный профессиональный опыт, который расширит ваши профессиональные горизонты"
Университетский курс в области кардиореспираторных патологий у пациентов со сложной хронической патологией
Откройте для себя возможность продвинуть свою медицинскую карьеру, пройдя Университетский курс в области кардиореспираторных патологий у пациентов со сожной хронической патологией. В Технологическом университете TECH мы предлагаем вам уникальный образовательный опыт, который позволит вам приобрести специализированные знания в области медицины, сфокусированные на комплексном ведении пациентов с хроническими кардиореспираторными заболеваниями. Наша программа представлена в формате онлайн-курса, разработанного для того, чтобы вписаться в ваш плотный график и обеспечить вам необходимую гибкость. Имея доступ к высококачественному образовательному контенту из любого места, вы сможете продолжить обучение без ущерба для своих профессиональных обязанностей. Мы известны своей приверженностью к академическому совершенству и подготовке выдающихся профессионалов в области медицины. На этом университетском курсе вы погрузитесь в учебную программу, в которой всесторонне рассматриваются сложности кардиореспираторных заболеваний у хронических пациентов.
Получите сертификат в лучшей медицинской школе Испании
Будучи студентом TECH, вы получите доступ к передовым ресурсам и самым современным технологиям, которые обогатят ваш опыт обучения. Преподаватели-эксперты в этой области будут вести вас через клинические кейсы, тематические исследования и стажировки, которые подготовят вас к решению реальных задач в медицинской среде. В основе нашей программы лежит глубокое понимание кардиореспираторных патологий. Вы научитесь эффективно оценивать, диагностировать и лечить пациентов с хроническими заболеваниями, учитывая такие аспекты, как устранение симптомов, профилактика осложнений и общее благополучие человека, о котором вы заботитесь. После успешного окончания университетского курса по кардиореспираторным патологиям вы не только получите сертификат, одобренный Технологическим университетом TECH, но и будете готовы к успешной медицинской практике и внесёте значительный вклад в здоровье пациентов с хроническими кардиореспираторными заболеваниями. Сделайте следующий шаг в своей медицинской карьере и станьте экспертом в области специализированной медицины!